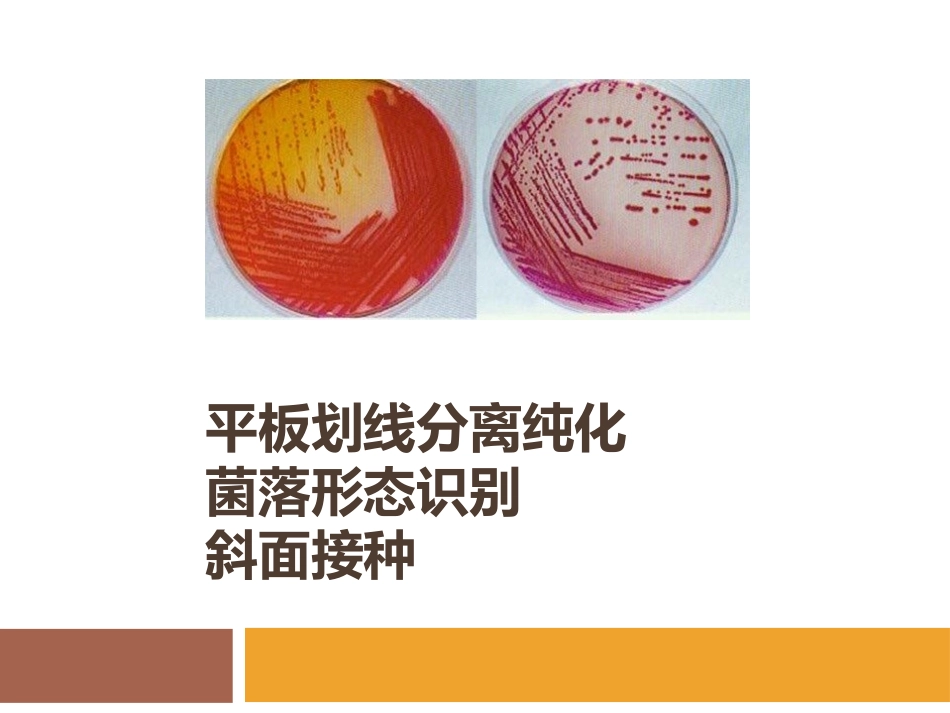

平板划线分离纯化菌落形态识别斜面接种了解平板划线法的基本原理,掌握其操作方法掌握无菌操作法移接斜面菌种的步骤和方法掌握常用的简易菌种保藏法熟悉细菌、放线菌、酵母菌和霉菌的菌落形态特征,并对一批未知菌落进行识别实验目的平板划线法是指把杂菌样品通过在平板表面划线稀释而获得单菌落的方法。一般是将混杂在一起的不同种微生物或同种微生物群体中的不同细胞,通过在分区的平板表面作多次划线稀释,形成较多的独立分布的单个细胞,经培养而繁殖成相互独立的多个单菌落。通常认为这种单菌落就是某个微生物的“纯种”在实际操作中,要获得可靠的纯种微生物,需进行多次划线分离实验原理(实验教材P110)平板、斜面、接种环超净工作台土壤溶液大肠杆菌和酵母菌的混合菌恒温培养箱材料仪器实验流程消毒平板划线接种培养清洁卫生平板划线操作示意图斜面接种1.烧环和试管口2.拔塞3.接种4.加塞5.烧环斜面接种接种斜面接种(实验教材P8)斜面培养情况(实验教材P12)•观察细菌、放线菌、酵母菌、霉菌等微生物具体菌种菌落的形态特征。•总结几类微生物菌落的一般特征并能识别。(二)各类微生物菌落特征观察菌落形态:形状,边缘情况大小:表面状况:湿润、粘稠或干燥,隆起或扁平,厚或薄,是否粉末状质地:致密或疏松蔓延程度:与培养基结合程度颜色(正面、反面、边沿、中心)气味四大类微生物识别要点(实验教程P18)菌落湿润,正反面、中央与边缘颜色一致干燥,正反面、中央与边缘颜色不一小而扁平小小大大小而隆起大而扁平大而隆起致密致密疏松霉菌细菌……酵母菌……放线菌微生物菌落形态描述(实验教程P18)菌落形态观察记录1.土壤3个平板分别对应三个表格,提前画好空表格2.判断每个平板中有多少种不同形态的菌落。3.每种形态的菌落选取其中一个典型方便观察的菌落作为该形态菌落来记录。4.连续观察3天。记录同一个菌落形态随培养时间的变化情况。5.如果后继时间平板中出现新形态的菌落,需增加记录该形态菌落。6.当场用记录本做好记录,然后老师签名确认。菌落号培养时间湿干菌落描述判断结果厚薄大小松密大小表面边缘隆起形状颜色透明度正面反面水溶色素11d2d3d21d2d3d31d2d3d未知菌落识别结果记录(实验教材P21)细菌菌落特征:细菌菌落特征:凝胶状、表面较光滑、湿润、与培养基结合不紧密,易挑取,正反颜色一致。酵母菌菌落特征(与细菌相似酵母菌菌落特征(与细菌相似))::比细菌大而厚,不透明,表面光滑、湿润、粘稠,易用针挑起。多呈乳白色,少数呈红色。YeastBacteria放线菌特征放线菌特征::致密、坚硬、多皱、不易用针挑起,不透明。孢子成熟后,表面粉末状,干燥(常有土腥味)。干燥霉菌的菌落特征比细菌菌落大,由菌丝组成疏松的绒毛状、絮状或蜘蛛网状,有的无固定大小,延至整个培养基中,产色素,使菌落显色。